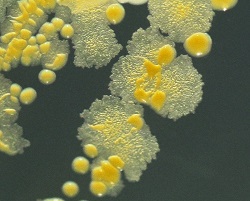
img 9696

Nu se poate nega faptul ca umbland descult vara prin gradina atunci cand udam rosiile sau cand plivim buruienile sa nu simtim o stare de bine, dar nu stim insa care este motivul stiintific al acestei stari.
Profesorul Christopher Lowry, alaturi de o echipa de cercetatori din cadrul Centrului de Neurostiinte de la Universtitatea Colorado Boulder, SUA, a publicat un studiul despre o bacterie specifica solului, numita Mycobacterium vaccae, care are un rolul declansator al comportamentului emotional. Cu alte cuvinte, bacteria are calitati antidepresive. “Solul, si in special cel ce are materie organica din abundenta, contine bacterii saprofite, ceea ce inseamna ca ele traiesc din materia organica moarta si lasata in descompunere, cum ar fi frunzele“, spune Lowry. Aceste bacterii, spune el, au rol deosebit in prevenirea si tratarea bolilor, ca astmul, tulburarile depresive majore, precum stresul post-traumatic, caracterizate prin inflamatie ridicata.

Reglementarea sistemului imunitar este intr-adevar legata de biodiversitatea mediului natural. Un om nu este un individ, ci un ecosistem, in care traiesc multi microbi (in special in intestine). ”Aceste bacterii constituie, in corpul uman, la randul lor un organism numit microbiota, la fel ca ficatul sau creierul”, spune Graham Rook, profesor la Centrul pentru Microbiologie Clinica de la Universitatea din Londra. Acesta arata ca o parte din microbiota provine din mediul inconjurator, inclusiv din gradina, unde suntem expusi la microorganisme benefice. Tocmai datorita acestui fapt, se constata ca problemele psihice sunt mai frecvente in mediul urban decat in mediul rural, si de aceea sunt recomandate mai multe spatii verzi, pentru a exista o biodiversiate microbiana mai bogata in orase, iar oamenii fiind expusi la bacteriile din mediu isi vor reface mai repede sanatatea. S-a demonstrat, astfel, ca mai exista, inca un motiv intemeiat ca sa mergem in gradina si sa ne murdarim pe maini si pe picioare.










